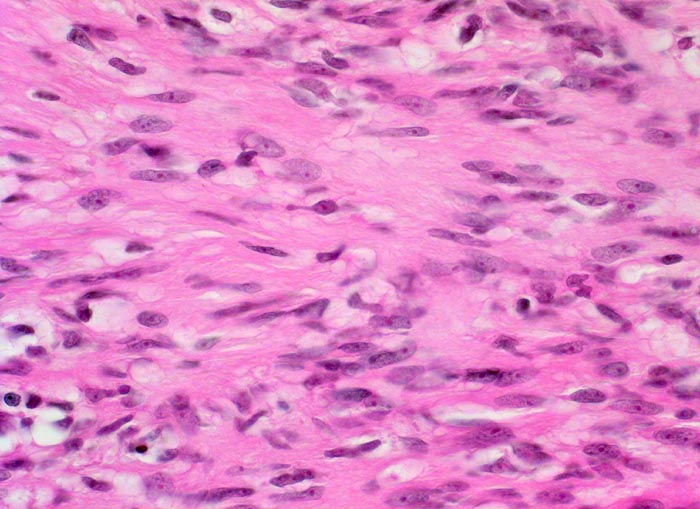

PathoPic – image database / PathoPic ID 4295 - Schwannom: Antoni A Muster
de
Diagnose
Schwannom: Antoni A Muster
Diagnose Gruppe
benigner Tumor
Topographie
Muskel, untere Extremität
Topographie Gruppe
Weichteile
Beschreibung
Kompakte spindelzellige parallel ausgerichtete Tumorzellverbände (Antoni A Muster).
Klinik
Tumor im Musculus soleus, 2cm Durchmesser
Bilder Typ
Histologie
Vergrösserung
400
Alter
61
Geschlecht
unbekannt
Datum
Ersteintrag: 05.04.2002
Update: 04.02.2024